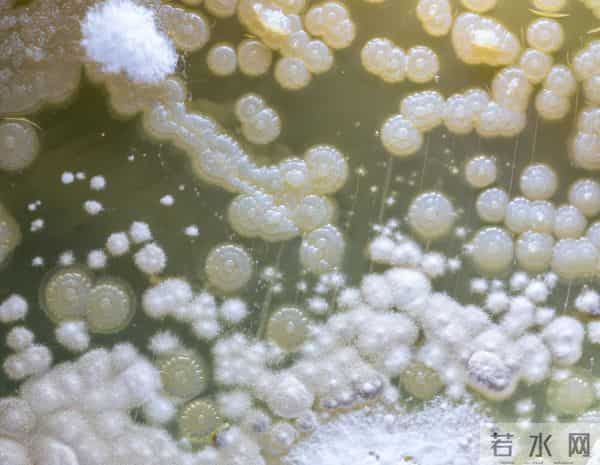
染发致癌是真的吗？哈佛大学调查12万人持续36年，结论终于出来了

染发致癌是真的吗?哈佛大学调查12万人持续36年,结论终于出来了

“你染发得挺自然啊!不过听说染发会致癌,你就不担心吗?”
刚过完五十岁的王阿姨,站在自家镜子前整理着一头新染的深栗色短发。她对“老去的白发”既无奈又憧憬新颜。好友刘姨却一脸忧心地提醒,“新闻说染发剂危险,身边的老姐妹有人用完就觉得不对劲,还总有人说‘染发=癌症高发’……”

染发到底安不安全?是不是如坊间传闻那样“白发换彩发,健康换坏命”?哈佛大学一个“12万人、36年跟踪”的大调查,给出了答案。到底经常染发,真的会导致癌症吗?哪些成分可能藏隐患?普通人又该如何科学选择、规避风险?那么,科学到底是怎么说的?
权威解读靠数据,哈佛大学公共卫生学院对12万多名美国成年人进行长达36年的追踪调查,其研究结果在《英国医学会杂志》(BMJ)等权威刊物发布。
调查重点分析了经常使用染发剂的人群,与未使用者之间的癌症发病率、类型与死亡率。
研究要点如下:36年追踪,累计监测约12万人次,数据覆盖多种染发习惯、年龄、性别等参数;覆盖了乳腺癌、膀胱癌、淋巴瘤、白血病等多种主流肿瘤类型,主要检测对象以常规家用染发为主,而非特殊工业染发暴露。

结果如何?总体而言,普通染发者与非染发者相比,“所有癌症总体发病风险”无显著增加;部分类型肿瘤(如乳腺癌)有微弱上升趋势,但数据波动在统计偏差范围内,绝大多数未达显著相关。
这也再次符合此前世界卫生组织(WHO)和中国疾控中心给出的共识:合规生产、正规途径获得的染发剂,其致癌风险极低,“适量、合规、间隔使用”情况下,对健康成年人不会构成明确威胁。
但这是否意味着所有染发剂都安全?隐患又藏在哪些环节?
长期染发后,身体可能出现的这些变化,你了解吗?染发剂属于化工混合物,个别高风险成分依旧需要关注。调研发现,长期、大剂量染发的个体,在特殊条件下,可能出现健康隐患,主要体现在以下几个方面:
个别染发成分在动物实验中显示潜在风险
部分芳香胺类物质(如对苯二胺)在实验室环境下,与小鼠膀胱肿瘤存在弱关联。但日常合规染发剂浓度极低,多数生产厂家已淘汰高风险原料;合规产品剂量远不足以达到实验中诱发病变的剂量。
频繁接触染发剂者,有轻度皮肤过敏、头皮刺激风险
调查显示超5%敏感体质人群可能出现皮炎、瘙痒、红肿、脱屑等反应。此类多为接触性过敏症,诱发机制与癌症无关,停止使用可自愈。
少数人群遗传易感或代谢异常
极个别基因型易感者,因代谢产物残留,长期高频、全头深色染发,或有提升膀胱癌风险,但普通人群几率极低。
存在“非法添加剂”和劣质三无产品诱发意外风险
黑市染发产品里曾被检出高浓度对苯二胺、双氧水等剧毒成分,引发急性中毒、过敏性休克,甚至危及生命;因此购买染发剂,必须锁定正规品牌、正规渠道,防止假冒伪劣产品侵害健康。

数据补充:哈佛研究显示,36年间定期染发女性乳腺癌风险上升约3%(统计意义不强);膀胱癌风险变化<1%,不具备统计学关联;部分深色染发剂产品风险略高于浅色,但总体绝对风险依然极低。
科学选择染发,这些方法帮你化险为夷染发致癌风险被夸大了,但合理、健康的染发习惯,依旧值得所有人关注。以下建议,简单可行,科学防护:
首选正规合规产品,认准“国家妆字号”标识:拒绝三无产品,坚持正规专柜/电商渠道;查看产品成分,不用过期、拆包产品。
减少频次,每年染发不应超过6次:给身体足够恢复和代谢时间;减少头皮暴露时长,涂抹时避开头皮、只染头发;
做好防护,染发前先做“皮肤斑贴测试”:3天前在耳后、手臂内侧涂一滴,确认无过敏再染;染发当天戴手套、涂隔离膏、及时冲洗残留。

尽量选择浅色、植物成分染发剂:天然成分风险更低:深色染发剂芳香胺比例高于浅色产品(高风险基因人群尤其需注意)。
孕妇、哺乳期、免疫异常或肾脏疾病者暂不建议染发:所有身体特殊人群都应提前咨询专业医师,根据实际状况评估。
染发后多喝水,多洗头,减少异物残留:建立良好生活习惯,从源头保护头皮和身体健康。
本文为健康知识科普,结合权威资料和个人观点撰写,部分情节为方便表达和阅读理解进行了适当虚构与润色,内容仅供参考,不能替代医生诊断。如感不适,请及时就医。收藏以备不时之需,分享转发给你关心的人!
参考资料:
中国疾病预防控制中心《染发剂安全风险评估指导意见》
中华医学会皮肤性病学分会《染发剂过敏与安全策略》
美国FDA《染发产品监管合规指南》
《中国肿瘤临床与预防杂志》2022年第3期 “染发行为与女性乳腺癌风险”
国家市场监管总局《化妆品管理条例(2021)》
本文标题:染发致癌是真的吗?哈佛大学调查12万人持续36年,结论终于出来了
本文链接:http://www.hniuzsjy.cn/mingxing/10692.html
声明:本站所有文章资源内容,如无特殊说明或标注,均为采集网络资源。如若本站内容侵犯了原著者的合法权益,可联系本站删除。
